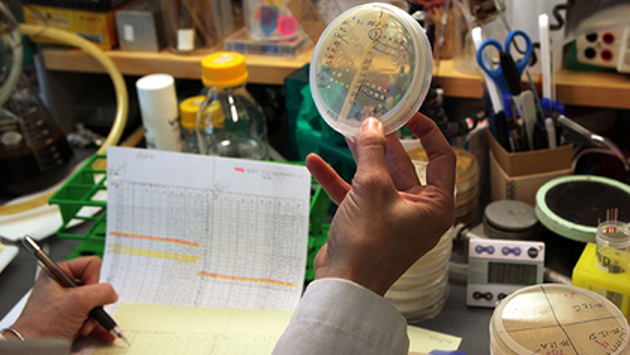

Ученые Калифорнийского университета в Лос-Анджелесе раскрыли механизм работы фермента теломеразы, который препятствует укорочению теломер и стабилизирует ДНК. По словам биологов, это поможет разработать методы по лечению рака и увеличения продолжительности жизни. Об этом сообщается в пресс-релизе на MedicalXpress. Концы хромосом, у человека состоящие из повторов TTAGGG, называются теломерами. Они предотвращают потерю генов во время митоза, поскольку ДНК-полимераза не способна синтезировать копию ДНК с самого конца, но каждый раз при репликации происходит укорочение теломеры. Когда теломеры становятся слишком короткими, клетки стареют и умирает. Теломераза восстанавливает теломеры, однако ее избыточная активность способствует раку, при котором злокачественные клетки становятся практически бессмертными. В ходе исследования были использованы одноклеточные микроорганизмы — инфузории тетрахимены Tetrahymena thermophila. С помощью криоэлектронной микроскопии ученые установили структуру теломеразы, связанной с теломерной ДНК. Известно, что каталитическое ядро теломеразы является обратной транскриптазой (ревертазой), которая участвует в синтезе ДНК на матрице РНК (этот процесс называется обратной транскрипцией). Кроме того, фермент состоит из теломеразной РНК (TER), являющейся шаблоном для синтеза теломерных повторов. Ученые определили, что в ревертазе существует область TRAP, которая играет решающую роль в добавлении небольших фрагментов ДНК к концам хромосом. При этом TRAP взаимодействует с доменом TEN, мутации в котором, как сообщают исследователи, нарушают активность фермента. Исследователи считают, что точное знание о структуре фермента поможет разработать методы «тонкой настройки» молекулы, улучшая или подавляя ее активность. В персом случае можно увеличить число циклов деления клеток, а во втором — воспрепятствовать развитию раковых опухолей.